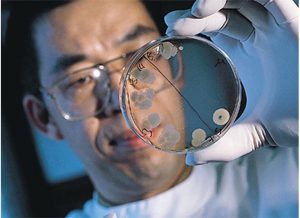

WHY PROTEK GUT WORKS
The science behind the ‘all round three in one supplement’
ONE OF OUR SCIENTISTS
Just one of our top scientists we have behind us at K & V and is our consultant for PROTEK. Dr James Tang, a veterinary immunologist developed an innovated process which can keep 95% allicin in our garlic after process. This technology has been widely used in animal feeding industry since 2010. Also lecturer at Microbiology & Immunology Dept. Veterinary College of NanJina Agricultural University during 1987 to 1992.
A BIT ABOUT THE HORSE DIGESTIVE TRACT
These microbes are actually found throughout the entire digestive tract. Most favour a pH-neutral environment, nearly all inhabit low digestive tract, the cecum and colon.
The goal of microbial balance involves keeping the numbers of cellulolytic high and the lactic-acid producers low. Further, as cellulolytic bacteria produce volatile fatty acids, the proliferation of pathogenic bacteria, like E. coli or salmonella, cannot occur. If the lactic acid-producing bacteria population starts growing, they produce enough lactic acid to influence the pH of the gut. Making it less hospitable for cellulolytic bacteria and more agreeable for the pathogenic bacteria. This is when problems may arise. How tolerant an animal is to changes in the pH before problems begin can be highly individual.
Balance is all about population control. When there is an overload of one kind of substrate that one type of bacteria digests. Then there is a population explosion of that type of bacteria. This affects the populations of the other types of bacteria, since they have less substrate to digest. The by-product of the digestion of the booming population may make the environment less habitable for the rest of the microbials. Shifts in the bacterial populations can cause digestive upset.
ALLICIN TO KEEP THE BALANCE
A normal high-forage diet will supply the microbes with exactly what they are looking for. To maintain balance, particularly the cellulolytic bacteria, protozoa, and fungi. Allicin is one of most high potency in antimicrobial activity. This is much less sensitive benefit micro orgasms compared to pathogenic bacteria, like E. coli or salmonella. Our Allicin can maintain the best balance of horse gut microbial populations.
The Allicin is from garlic but most garlic on the market do not contain much allicin due to high-temperature process. Dr James Tang, a veterinary immunologist developed an innovated process which can keep 95% allicin after process and this technology has been widely used in animal feeding industry since 2010
ANOTHER ONE OF OUR INGREDIENTS
Cinnamon oil in special microencapsulated format and works with allicin to work together syngically in the horses gut and provide optimal balanced microbial population in the equine digestive tract.
Cinnamon oil is one of the most powerful natural antimicrobial activities in all essential oils and the same as allicin. Cinnamaldehyde, main activity compound in cinnamon oil is much less sensitive to benefit microorganisms compared to pathogenic bacteria, like E. coli or salmonella.
Unlocking the Power of Allicin in Garlic
The Revolutionary Work of Dr James Tang
I can’t wait to share some exciting developments from the world of veterinary science that transform the way we approach animal health.
For over a decade, James Tang, has been making waves in the animal feeding industry with ground breaking research.
Our scientist Dr. Tang, a veterinary immunologist, has developed a unique process that allows us to preserve 95% of allicin while maintaining its potent benefits for animals.
But what exactly is allicin, and why should we care?
The compound Allicin is found in garlic, known for its impressive antimicrobial and anti-inflammatory properties. It’s a powerhouse ingredient that can significantly boost the health and well-being of animals. Given the increasing focus on holistic health in pet and livestock care, Tang’s innovation couldn’t come at a better time.
Since 2010, Tang’s process has been widely utilized in the animal feed industry, elevating the quality of gut health supplements. One standout product from this innovation is the **Gut Supplement & Digestive Health**, which contains an impressive 8% of allicin! This remarkable formulation promotes better digestion and bolster the immune system, making it a must-have for any animal lover.
What sets our garlic apart is its extraordinary origin.
We source our garlic from the pristine environment of Cangshan, China. This region is home to unique garlic species that each have fewer than seven cloves per bulb. These original varieties boast a higher concentration of beneficial compounds than your average garlic. The less-clove garlic is often more potent; it’s an edge that aligns perfectly withTang’s vision for maximizing allicin retention.
Garlic
The significance of this work goes beyond mere numbers; it represents a shift toward more natural and effective solutions for animal health.
By integrating these powerful garlic extracts into animal feeding practices, we are not only enhancing gut health but also supporting the overall well-being of animals in our care.
So, what does this mean for you?
Incorporating gut health supplements based on James Tang’s research could be a game changer. Knowing your animals are receiving a product that preserves the natural potency of garlic to improve their health and vitality!
As we continue to delve deeper into the potential of veterinary immunology and natural supplementation. It’s exhilarating to think about what else might be in store. Our scientist James Tang’s work teaches us that science, backed by natural ingredients, holds the keys to a healthier future for our animals.
Conclusion
Feel free to reach out if you’d like more information about Protek 3 in 1, or if you have questions regarding how to support your animals’ digestive health. Let’s unlock the potential of natural ingredients together!